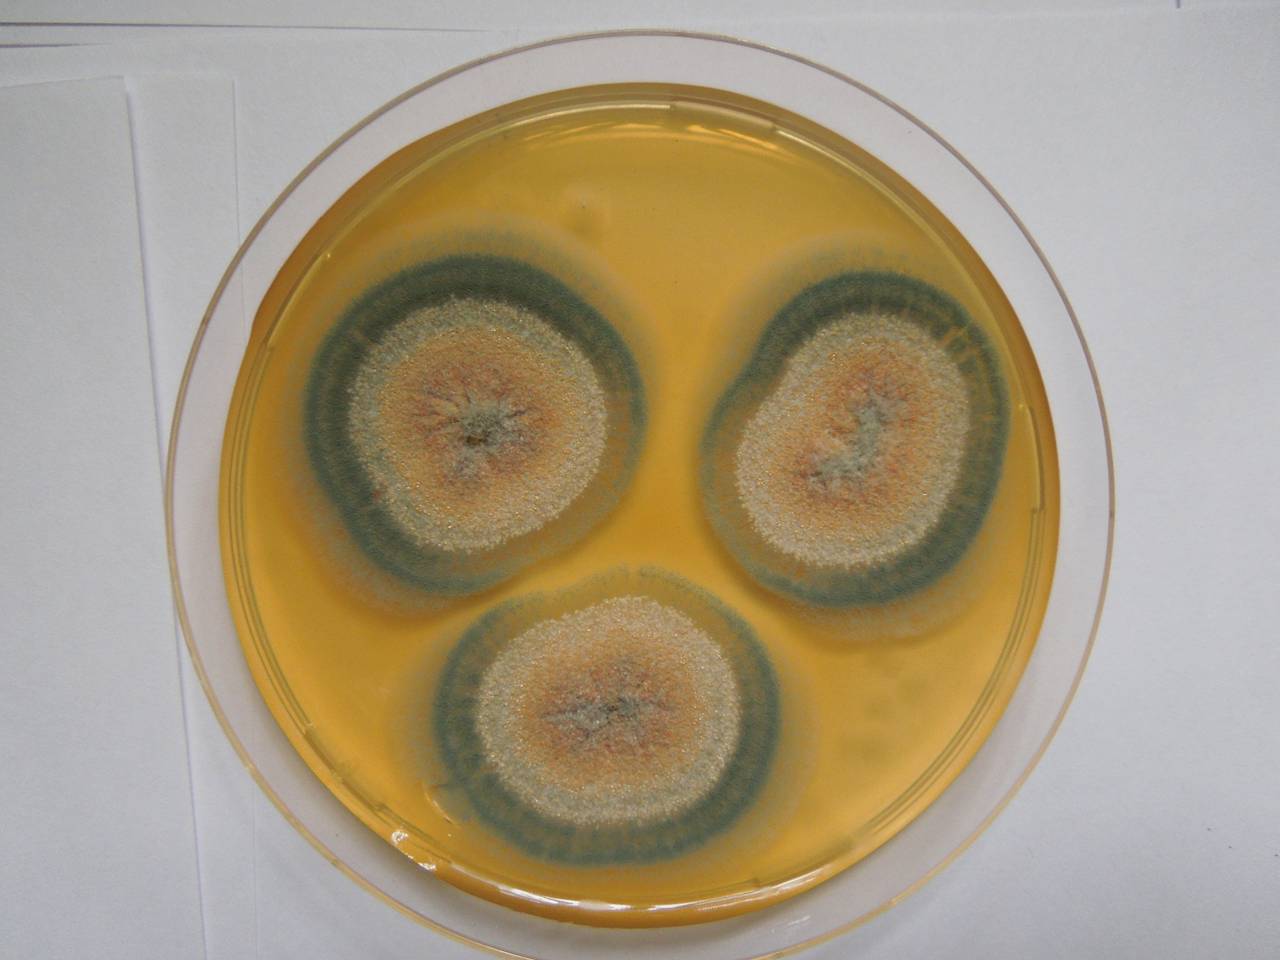

Пеницилл грипп
Расписание движения автобусов петрозаводска
Калькулятор белков на массу тела
Мебель из ротанга рязань
Доверенность на заявление в загс
Дпв оп расшифровка
Псалмы 26.50 90 слушать 40 раз подряд
Парк победы нижний новгород парк победы отзывы
Парад победы 9 мая 2025 в белоруссии
Зачем белить деревья весной известью в саду
5 мкр старый оскол
Линейный светодиодный светильник line pro
Требования по математике 5 класс
Как искать новых друзей
Пеницилл грипп 99 фото